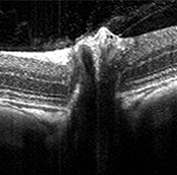

Ocular Models of Pharmacology and Efficacy
Comparative Biosciences, Inc. a premier ocular research CRO, provides a large variety of validated discovery and translational preclinical ophthalmic research studies including ocular efficacy, pharmacology, or in vivo indications. Our ophthalmic models include macular degeneration, retinopathies, inflammation, dry eye, glaucoma, and degenerative disease. We also have capabilities in ocular device implantation and evaluation. Further, we have capabilities in corneal epithelial and endothelial assessments. CBI scientists are available to discuss these models in more detail. We are also willing to work with our sponsors to develop unique or customized models.
CBI provides special assessment techniques including, OCT (See our OCT video), ERG, gonioscopy, ocular ultrasound, tonometry, laser photocoagulation, slit lamp, funduscopy, retinal angiography, pachymetry, Schirmer and phenol red thread test, hypoxic or hyperoxic chambers.
CBI is also happy to be able to develop new, customized and novel ocular models in collaboration with our sponsors and to address special regulatory issues presented by the regulators.
We are happy to provide further information and validation data on our models upon request.
. For a full overview of our Ocular Studies, please download CBI Technical Bulletin: CBI-Technical Bulletin.Ocular
Validated Efficacy Ophthalmic Models available at CBI include:
Models of Angiogenesis and Macular Degeneration
- Choroidal neovascularization in mice, rats and pigs (laser-induced)
- Choroidal neovascularization in rabbits (laser-induced)
- Oxygen-induced retinopathy in mice and rats
- VEGF-induced choroidal neovascularization in rabbits
- Streptozotocin-induced retinopathy
- Senescent knockout mouse model of macular degeneration
Models of Inflammation
- Melanin-antigen associated anterior auto-immune uveitis in Lewis rats
- IRBP-antigen associated posterior inflammation in rodents
- LPS-induced acute inflammation in rabbits and rodents
- Ovalbumin-induced immune mediated inflammation in rabbits
- F48/80-induced acute inflammation in rabbits
- Corneal infection
Models of Glaucoma
- Laser-induced episcleral cautery for glaucoma in rats
- Chymotrypsin-induced glaucoma in rabbits
Models of Dry Eye
- Concanavalin A-induced dry eye in rabbits
- Botulinum-induced dry eye in mice
- Scopolamine-induced dry eye in mice
- Atropine-induced dry eye in rabbit and mice
Device Implantation
- Intraocular stents for glaucoma or drug delivery
- Corneal rings
- Punctal plugs
- Artificial lens insertion or removal
- Corneal surgery
- Corneal debridement
- Intraocular implants
- Corneal wound healing
- Endothelial damage or disease indications
Models of Corneal Injury, Inflammation and Healing
- Heptanol-induced corneal erosion in rabbits
- Suture-induced inflammation in rodents
- Corneal incision
- Bacterial or infectious models of ocular inflammation
Models of Ocular Degeneration
- MNU-induced retinitis pigmentosa
- Vitreal detachment
Contact Lens Testing
Ocular Implants
- Intraocular stents
- Punctal plugs,
- Drug delivery systems
- Glaucoma treatment
Hyper Oxygenation
- Low or high oxygen chambers to induce oxygen-induced retinopathy of prematurity or pulmonary bronchodysplasia
Stem Cell Treatment and Administration
Vitreal Detachment and Vitreal Integrity
Ocular Histopathology and Immunohistochemistry
- GLP histopathology for ocular toxicology studies: ocular examination of globe and adenexal structures
- Histopathologic examination of ocular tissues from research studies
- Ocular pharmacology models
- Ocular immunohistochemistry
- Retinal whole mount
Custom or Specialized Models
CBI is happy to design and develop novel models of ocular pharmacology and to address special issues related to ocular toxicology.
Ocular Assessments
CBI provides special techniques including, OCT (See our OCT video), ERG, ocular ultrasound, gonioscopy, tonometry, laser photocoagulation, slit lamp, funduscopy, pachymetry, Schirmer test, phenol red thread test, hypoxic or hyperoxic chambers, retinal angiography, device implantation, lens removal or insertion, whole mount preparation, ocular histology and immunohistochemistry and ocular photography.
- OCT
- Microscopy for Ocular Endothelium
- ERG
- Laser Photocoagulation
- Ocular Ultrasound
- Gonioscopy
- Slit Lamp Biomicroscopy
- Funduscopy and Angiography
- Tonometry
- Pachymetry
- Hyper or Hypo-oxic Chambers
- Schirmer and Phenol Red Thread Test
- Pupil Measurements
- Histology, Immunohistochemistry, Retinal Whole Mounts
Ocular Routes of Administration
- Topical
- Intracameral
- Intrascleral
- Intrastromal
- Intravitreal
- Periocular
- Retrobulbar
- Subconjunctival
- Subretinal
- Subtenon
- Systemic Routes
- Trans-Scleral
- Implant or Device or Combination
- Contact Lens, Punctal Plugs
Formulations for Ocular Efficacy Studies
- Injectables
- Topical Creams, Ointments, Gels, Drops
- Implant and Inserts
- Microspheres and Particles
- Patches
- Gene therapy and Regenerative Medicine
- Stem Cells
- Additional Formulations and Radiolabeled Studies are also available.
Histology Images